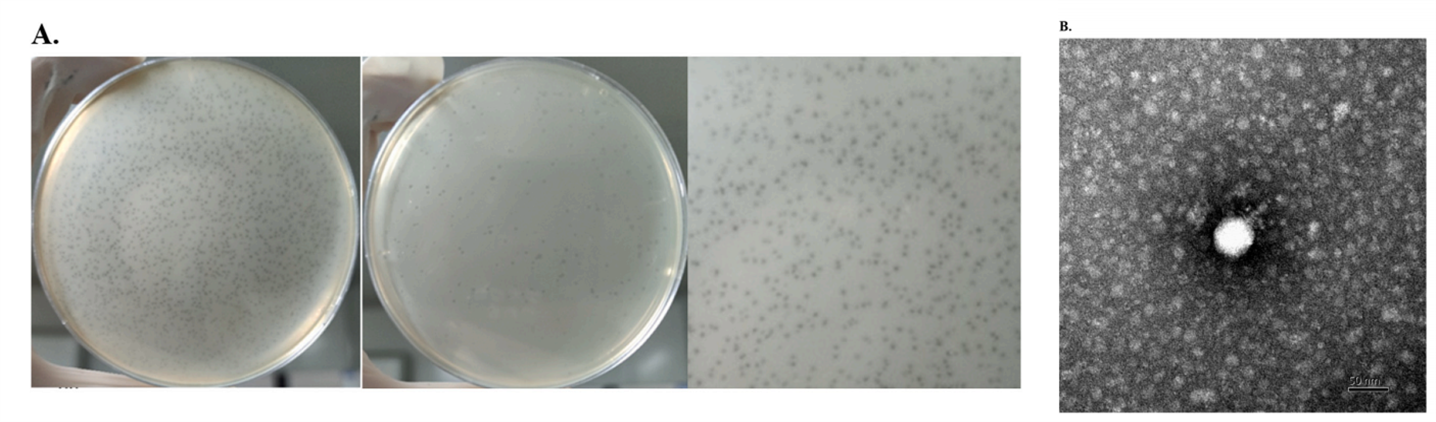
2.png

2022-07-05

《International Journal of Food Microbiology》
影响因子:5.277
派森诺与江苏大学合作,在食品微生物领域《International Journal of Food Microbiology》发表新研究成果!本研究从鸡粪便中,分离到产气荚膜梭菌特异性裂解新噬菌体HN02,该噬菌体具有良好的pH和温度耐受性、宿主范围较广。通过裂解活性试验,噬菌体HN02表现出良好的抗菌作用,可作为抗裂剂肉制品中产气荚膜梭菌的生物防治剂。
01 研究背景
产气荚膜杆菌(C. perfringens)是革兰氏阳性、厌氧、产孢子的杆菌,通常存在于人和动物的肠道中。C. perfringens的产肠毒素菌株可引起食物中毒,如造成人类腹泻和急性腹部绞痛,这被认为是工业化国家常见的细菌食物中毒剂。目前,大多数的干预措施包括用化学添加剂(硝酸盐和亚硝酸盐、磷酸盐、有机酸)加热或处理食品,这些添加剂会对产品的味道和质量产生不利影响。
噬菌体(噬菌体)和内毒素等一直备受关注,噬菌体可以作为抗生素的有效替代品来控制病原体。许多研究集中在开发噬菌体或噬菌体溶菌素来对抗与肉鸡坏死性肠炎密切相关的C. perfringens。在本研究中,分离得到一种新的噬菌体HN02作为预防和控制鸡产C. perfringens的替代方法。本研究结果为控制C. perfringens在鸡体内的污染和控制C. perfringens中毒事件的发生提供了一种新的途径。
02 研究材料与方法
1.实验材料
在陕西省养鸡场从鸡粪便中分离到C. perfringens菌株ATCC 13124和20株其他产气荚膜梭菌。以ATCC 13124为宿主菌株,从中分离出噬菌体。
2.测序平台
Illumina NovaSeq
3.分析内容
噬菌体基因组组装注释、系统发育树构建、宿主范围鉴定、MOI和一步生长曲线鉴定、热稳定性和PH稳定性鉴定、噬菌体吸附和裂解分析等。
03 研究结果
1.C. perfringens噬菌体的分离与鉴定
以C. perfringens ATCC 13124为宿主菌株,从鸡粪中分离到一种新的噬菌体HN02。HN02噬菌体能够在宿主上形成清晰的菌斑,其直径约为0.1 mm(图1A)。形态学观察显示,HN02噬菌体具有等距多面体头部(直径为49.38±1.07 nm)和短尾(33.95±1.08 nm)(图1B)。根据国际病毒分类委员会(ICTV), HN02被划入足病毒科。当噬菌体感染MOI 1宿主菌株时,噬菌体的滴度更高,为1.09 × 109 PFU/mL(图2B),因此,HN02噬菌体的最佳MOI应为1。在最优MOI条件下,测定了植株的一步生长曲线。从一步生长曲线看,HN02噬菌体潜伏期约为20 min,平均爆发大小约为27.67 PFU/细胞(图2B)。
图1 感染C. perfringens的噬菌体vB_CpeP_HN02的特性

图2 (A)最佳感染多样性(MOI);(B)一步生长曲线
2.噬菌体HN02的宿主范围鉴定
为确定HN02噬菌体的宿主范围,采用斑点法对C. perfringens和其他革兰氏阳性菌和革兰氏阴性菌进行检测。研究人员用20株A型C. perfringens确定了噬菌体HN02的宿主范围。噬菌体HN02对C. perfringens分离株的宿主范围较宽,对42.86%的分离株有不同程度的裂解作用,这与之前报道的C. perfringens噬菌体CPS2不同。结果表明,HN02噬菌体仅能感染C. perfringens,提示该噬菌体可能具有一个C. perfringens感染的菌株特异性宿主。
3.噬菌体HN02的温度和pH敏感性鉴定
HN02的宿主裂解活性应在各种压力条件下保持稳定,包括温度和pH。在30、40、50和60℃孵育30分钟和60分钟后,噬菌体pfu数量没有显著变化。然而,在70℃孵育60分钟后,噬菌体滴度降低了0.96 log(图3A)。80℃孵育30 min和60 min后,噬菌体pfu分别降低4.74 log和4.64 log 。所有噬菌体在90℃孵育30分钟后均死亡。这些结果表明,噬菌体HN02在低于70℃的温度下是热稳定的。pH敏感性结果显示,噬菌体HN02在培养2 h时,pH在5-11保持相当稳定(图3B)。可以看出,噬菌体对酸、碱和高温具有良好的耐受性(图3B)。

图3 噬菌体噬菌体HN02的生物学特性
4.噬菌体吸附和裂解活性
由于吸附是噬菌体感染的第一步,研究人员通过测定噬菌体与C. perfringens ATCC 13124孵育后,培养基中自由噬菌体斑块形成单位来确定噬菌体HN02对C. perfringens菌的吸附效果。结果表明,45%的噬菌体颗粒被ATCC 13124吸附。然而,与ATCC 13124孵育20分钟后,培养基中游离噬菌体的pfu明显减少(图4A)。与C. perfringens噬菌体CPS2相比,HN02的吸附时间更短,效率更高。MOI为1000时,5 h内噬菌体HN02几乎能将寄主菌株完全裂解,MOI为100时寄主浓度虽未下降,但仍能看到一定的抑制活性。同样,当MOI为0.01和0.001时,宿主菌株的OD600值受到噬菌体的抑制,在孵育4 h内生长缓慢。4 h后,宿主菌株浓度略有下降,与初始水平相当(图4)。因此,在今后噬菌体的应用中,用量和裂解时间应加以考虑。

图4 噬菌体HN02的吸附和溶解活性
5.噬菌体序列分析
HN02的全基因组为线性双链DNA,长度为17754 bp,与C. perfringens噬菌体ΦCP24R具有高度的同源性(图5)。其GC含量低(约28.2%),编码率为88.07%,每个ORF的平均长度约为710.73 bp,噬菌体HN02的基因组序列在末端有大量的反向重复,7个启动子。18个ORFs与噬菌体ΦCP24R高度相似。在HN02蛋白中发现的酶包括B型DNA聚合酶(HN02_19),与噬菌体梭菌ΦCP24R和ΦCPV1的相似性最高。HN02_12经鉴定为溶菌酶-肽酶,为足毒病毒科成员所独有,它包括一个尾结构域(PHA00380)、一个溶菌酶结构域(CL00222)和一个肽酶结构域(PF01551)。ORF HN02_18与芽孢杆菌噬菌体phi29 DNA包壳蛋白Gp16 (YP_002004545.1)相似,可以通过DNA包装atp酶活性形成包装马达。在HN02剩余的预测基因中,有8个与phi24R的假蛋白有显著相似性,4个orf在多个数据库中发现与蛋白质无显著相似性。

图5 基因组圈图
主要衣壳蛋白和大末端酶亚基通常被认为是噬菌体的保守序列,已被用于许多噬菌体的系统发育研究。为研究HN02噬菌体与其他C. perfringens噬菌体之间的关系,利用MEGA6和噬菌体主要衣壳蛋白(HN02_14)建立系统发育树。采用邻接法,重复1000次。当同源性设置为30%时,只有9个C. perfringens噬菌体蛋白被分类。在主要衣壳蛋白树中,HN02与噬菌体phi24R (NC_019523.1)和CPD2 (NC_048738.1)形成单独的簇(图6)。这些进化分析表明,HN02噬菌体是足病毒科的新成员。HN02与ΦCP24R的同源性最高,这两种噬菌体均为C. perfringens噬菌体。综上所述,HN02是一种新型的强毒性噬菌体,对C. perfringens具有良好的抗菌作用。

图6 衣壳蛋白的系统发育树
6.HN02噬菌体对鸡胸脯产气荚膜杆菌失活的研究
C. perfringens是与家禽消费有关的普遍的食源性病原体之一。因此,利用噬菌体控制生鸡胸肉在屠宰加工过程中的污染,对保证食品安全更有意义。在4℃的鸡肉中添加稀释的C. perfringens噬菌体,从1×106 PFU/g到1×1010 PFU/g(图7)。噬菌体HN02对C. perfringens表现出典型的剂量依赖性抑制作用。随着噬菌体剂量的减少,抑制效率也降低。而1×1010 PFU/g噬菌体HN02处理48 h后可完全裂解C. perfringens。C. perfringens数量的减少与噬菌体密度成正比,即噬菌体浓度越高,C. perfringens数量的减少幅度越大。在抑菌过程中,不同组的噬菌体浓度变化不明显,72h后仍与初始水平相当。

图7 噬菌体HN02基因组启动子的预测
04结 论
本研究评估了一种新的可溶性噬菌体HN02作为预防和控制鸡C. perfringens的替代方法。研究结果表明,HN02噬菌体处理人工污染的鸡肉后,鸡肉表面C. perfringens的数量明显减少,且具有较好的耐pH和耐温性。因此,本研究认为HN02噬菌体可用于控制C. perfringens在肉制品尤其是鸡肉中的污染,可有效降低该菌污染的风险和由该菌引起的中毒事件的发生。
本研究的denovo测序和部分数据分析由上海派森诺生物科技有限公司完成。如需进一步讨论,欢迎发邮件或者致电我们哟(邮箱地址:microsupport@personalbio.cn,联系电话:025-56165883-832)!
文章索引:Yuan, Tab , et al. "Virulent phage vB_CpeP_HN02 inhibits Clostridium perfringens on the surface of the chicken meat - ScienceDirect." .https://doi.org/10.1016/j.ijfoodmicro.2021.109514